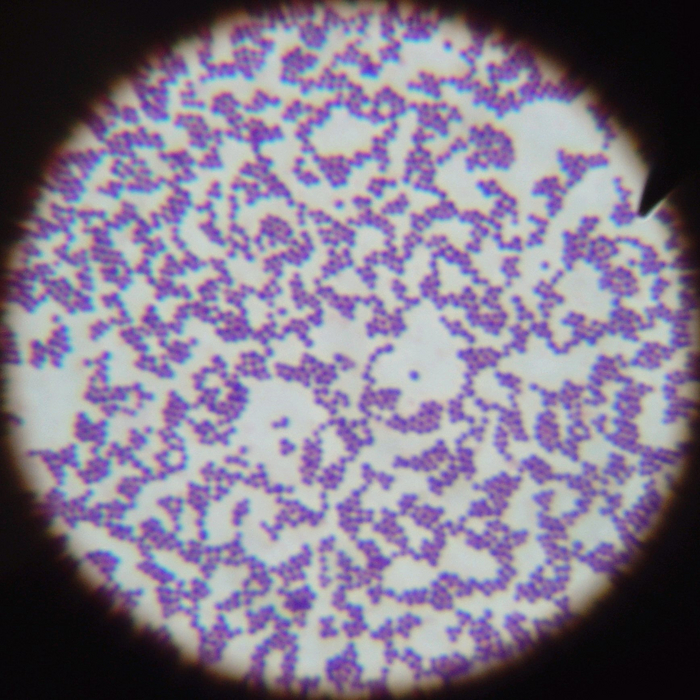
Калейдоскоп врача лабораторной диагностики.

Боль в плече в результате системных заболеваний соединительной ткани
(аутоиммунных, метаболических и др.).
Наконец, мы дошли до истинной ревматологии, тех заболеваний, подозревая которые другие специалисты дают однозначный совет: “Вам к ревматологу!”.
Рассмотрим их в контексте поражения плечевых суставов.
Уже обсудили:
хроническое аутоиммунное и аутовоспалительное заболевание суставов и внутренних органов.
Проявляется: симметричное поражение (не всегда), боль, ограничение движений.
Классические проявления: симметричное воспаление суставов мелких кистей, стоп, коленных.
Лабораторно: повышение СОЭ, СРБ, ревматоидного фактора (опционально), АЦЦП, АМЦВ.
Инструментально: на рентгенограмме - сужение щели, эрозии, кисты, околосуставной остеопороз, подвывихи (при тяжелом течении).
на УЗИ - синовит, неровный кортикальный слой.
на МРТ- все вышеперечисленное в красивых картинках.
Группировка “Серонегативные спондилоартропатии” (анкилозирующий спондилит, псориатический спондилоартрит, реактивные артропатии).
Системные заболевания с поражением позвоночника, суставов, энтезисов, глаз.
Проявляется: ассиметричное поражение, боль, ограничение движений, боль в спине.
Классические проявления: боли в спине воспалительного характера (нарастают в покое, уменьшаются при физической активности), асимметричные боли в суставах, воспаление мест прикрепления сухожилий к костям.
Лабораторно: повышение СОЭ, СРБ (не всегда), РФ отрицательно.
Инструментально: на рентгенограмме - энтезофиты (воспаления мест прикрепления связок к костям), суставная щель может быть не сужена.
на УЗИ: синовит, выпот, энтезиты.
Системная красная волчанка.
аутоиммунное заболевание с многообразными вариантами поражения внутренних органов и суставов.
СКВ больше интересна с точки зрения высокой вероятности развития асептического некроза (из-за самого заболевания и лечение гормональными препаратами).
Асептический некроз головки плечевой кости занимает второе место по частоте встречаемости после тазобедренного.
Факторы риска - прием глюкокортикостероидов, системные заболевания соединительной ткани, алкоголь, травмы, тромбозы.
Проявляется: интенсивная острая боль, ограничение движений в суставе.
Инструментально: на рентгенограмме - деформация головки.
МРТ выявляет на начальных стадиях.
Подагра и другие микрокристаллические артриты.
Хронические заболевания с накоплением кристаллов мочевой кислоты (пирофосфата кальция, гидроксиапатита кальция) в тканях и бурной воспалительной реакцией.
Проявляется: острая боль, припухлость, покраснение, как правило односторонние, относительно быстро проходит после приема НПВП.
Классические проявления: острые боли в первом пальце стопы, с покраснением и припухлостью.
Лабораторно: в момент приступа - повышение СОЭ, СРБ, вне приступа - повышение мочевой кислоты в крови.
Инструментально: изменения на рентгенограмме выявляется в поздних стадиях - внутрикостные тофусы (отложения кристаллов мочевой кислоты в кости).
На УЗИ - “двойной контур” признаки отложения кристаллов, синовит во время приступа - могут обнаружены случайно до развития приступа.
Ревматическая полимиалгия.
Воспалительное заболевание старшей возрастной группы (от 50 лет) с острой боль в плечевом и тазовом поясе.
Проявляется: двусторонняя боль в шее, плечевом/тазовом поясе, скованность, усиливаются при движении.
Лабораторно: СОЭ более 40-50 мм/ч, значительное повышение СРБ.
Инструментально: на рентгенограмме характерных изменений нет.
На УЗИ может быть картина субдельтовидного бурсита, теносиновита длинной головки бицепса.
Фибромиалгия.
заболевание со стойкой невоспалительной скелетно-мышечной болью.
Проявляется: ноющие боли и скованность в плечевых суставах (а чаще во всем теле), усиливаются на стресс, нарушения психо-эмоциональный компонента.
Фибромиалгия является диагнозом исключения, когда мы отвергли другие заболевания.
Характерных лабораторных и инструментальных находок нет.
Что еще может проявляться болью в плече?
Поражение шейного отдела позвоночника. Шейная радикулопатия - боль по боковой поверхности плеча до пальцев (не всегда), боль в области лопатки.
Отраженные боли - в правом плече при патологии печени и желчного пузыря, левом плече при стенокардии и инфаркте миокарда; при патологии верхушки легкого.
Новообразования. Саркома.
Тревожные знаки: лихорадка, потеря веса, припухлость в области сустава, в подмышечной впадине. Диагностика при подозрении - МРТ.
Это завершающий материал по причинам боли в плече, задавайте вопросы, предлагайте идеи, комментируйте.
Для улучшения состояния суставов необходимо подписаться.
Имеются противопоказания, необходима консультация специалиста.